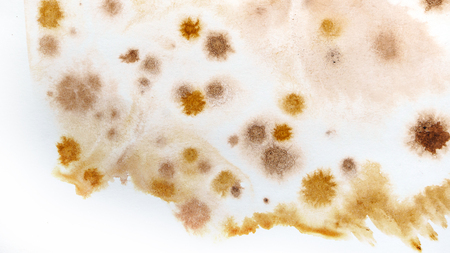
Abstract brown watercolor background. Splashes and strokes. High resolution texture. Modern Art. Hand drawing. Elements for creating brushes and textures.の写真素材

写真素材 - Abstract brown watercolor background. Splashes and strokes. High resolution texture. Modern Art. Hand drawing. Elements for creating brushes and textures.
作品情報
Abstract brown watercolor background. Splashes and strokes. High resolution texture. Modern Art. Hand drawing. Elements for creating brushes and textures.
- ID:122548114
- 作品種別:写真
- 作者名:Elena Vagengeim
キーワード
- abstract
- acrylic
- aquarelle
- art
- artistic
- babyish
- backdrop
- background
- banner
- brown
- brush
- canvas
- color
- colorful
- creative
- creativity
- daub
- decorate
- decoration
- design
- drawing
- drips
- element
- frame
- graphic
- grunge
- hand
- illustration
- image
- ink
- oil
- paint
- paper
- pattern
- silhouette
- sketch
- splash
- spot
- stain
- texture
- vibrant
- vintage
- wallpaper
- water
- watercolor
- watercolour
類似作品
Abstract waterc...
watercolor abst...
Abstract colorf...
Abstract artist...
watercolor pape...
horizontal brow...
A frothy mocha ...
Abstract waterc...
Beautiful brown...
Abstract waterc...
Soft colors ble...
Natural marble ...
Brown yellow be...
Abstract old gr...
watercolor pain...
scratched grung...
Abstract waterc...
great watercolo...
watercolor text...
Old paper textu...
watercolor pape...
Abstract waterc...
Original artwor...
Abstract artist...
horizontal brow...
great watercolo...
Abstract artist...
close up of abs...
Old paper textu...
Beige watercolo...
great watercolo...
A beautiful abs...
yellow-orange b...
Hand Painted Gr...
Texture of ston...
watercolor back...
the background ...
Abstract waterc...
Yellow brown or...
Watercolor stai...
Abstract waterc...
grunge backgrou...
Abstract waterc...
horizontal brow...
This artistic w...